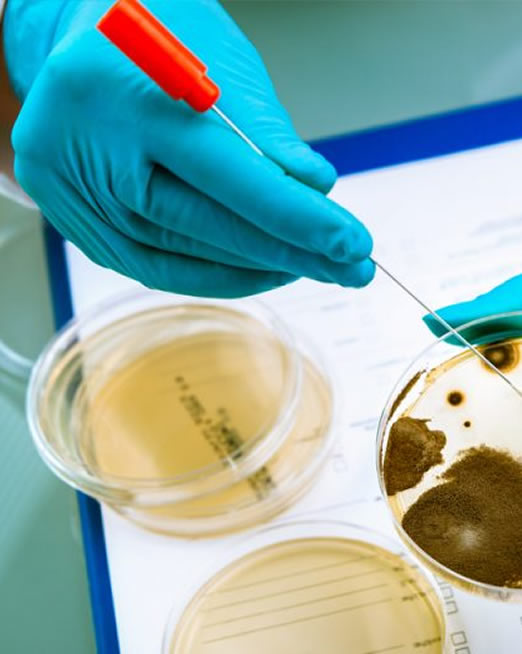

Fale Conosco
(31) 2564-0924
Anos de experiência
A P&D BIOTECH é uma empresa de produção de meios de cultura, voltada ao desenvolvimento e produção de meios de cultura padrão e especiais, com o objetivo de atender as necessidades dos laboratórios em diferentes seguimentos como farmacêuticos, cosméticos, veterinários, diagnósticos humano, agroindustriais e biológicos On Farm.
A empresa é formada por uma equipe técnica experiente composta por biólogos, farmacêuticos, químicos e técnicos em biotecnologia, apta a prestar aos seus clientes, soluções rápidas e personalizadas.
Buscamos constantemente pela excelência, perfeição e segurança do produto acabado, desde a aquisição de matéria prima, cadeia produtiva e o atendimento ao cliente.